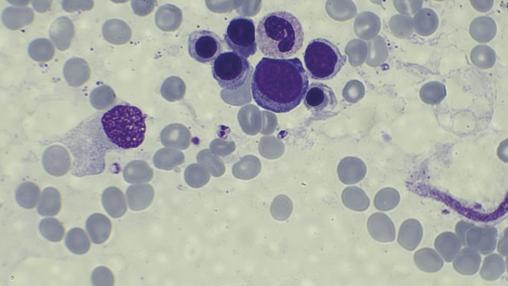

Cet homme de 35 ans, sans antécédents particuliers, avait depuis un mois une toux sèche avec une fièvre, des sueurs nocturnes, une asthénie et un amaigrissement de 10 kg. À l’examen, on notait des conjonctives décolorées, une splénomégalie et des adénopathies sous-mandibulaires. La biologie montrait une pancytopénie, un syndrome inflammatoire biologique, un taux de prothrombine bas (53 %). Sur la tomodensitométrie (TDM) thoracique, on notait un nodule pulmonaire excavé médiobasal droit (fig. 1 ). Des corps de leishmanies intra- et extramacrophagiques étaient trouvés au médullogramme (fig. 2 ). Le patient était traité par antimoniate de méglumine (Glucantime) à raison de 3 g/j pendant vingt jours ; sur la TDM de contrôle cinq mois après la guérison, le nodule pulmonaire s’était densifié (fig. 3 ).
L’atteinte pulmonaire dans la leishmaniose viscérale est considérée comme rare. Cependant, une toux sèche persistante est une caractéristique négligée, mais assez courante puisqu’elle est notée chez près de 83 % des patients.1 Cette atteinte est souvent rapportée chez les immunodéprimés, en particulier ceux infectés par le VIH.2 L’immunité protectrice contre la leishmaniose viscérale dépend de cytokines pro-inflammatoires comme le TNF-alpha, l’interleukine 12, et l’interféron gamma ; lorsqu’ils sont à un niveau bas, une formation de granulomes désorganisés est induite.3 Le diagnostic de leishmaniose viscérale doit être évoqué en présence d’un nodule pulmonaire solitaire même chez les sujets immunocompétents pour une prise en charge rapide.
Références
1. Kotsifas K, Metaxas E, Koutsouvelis I, et al. Visceral leishmaniasis with endobronchial involvement in an immunocompetent adult. Case Rep Med 2011;2011:561985.
2. Herwaldt BL. Leishmaniasis. Lancet 1999;354:1191-9.
3. Temesgen Ewunetu Andargie TE, Ejara ED. Pro- and anti-inflammatory cytokines in visceral leishmaniasis. J Cell Sci Ther 2015;6:1000206.
2. Herwaldt BL. Leishmaniasis. Lancet 1999;354:1191-9.
3. Temesgen Ewunetu Andargie TE, Ejara ED. Pro- and anti-inflammatory cytokines in visceral leishmaniasis. J Cell Sci Ther 2015;6:1000206.
Une question, un commentaire ?